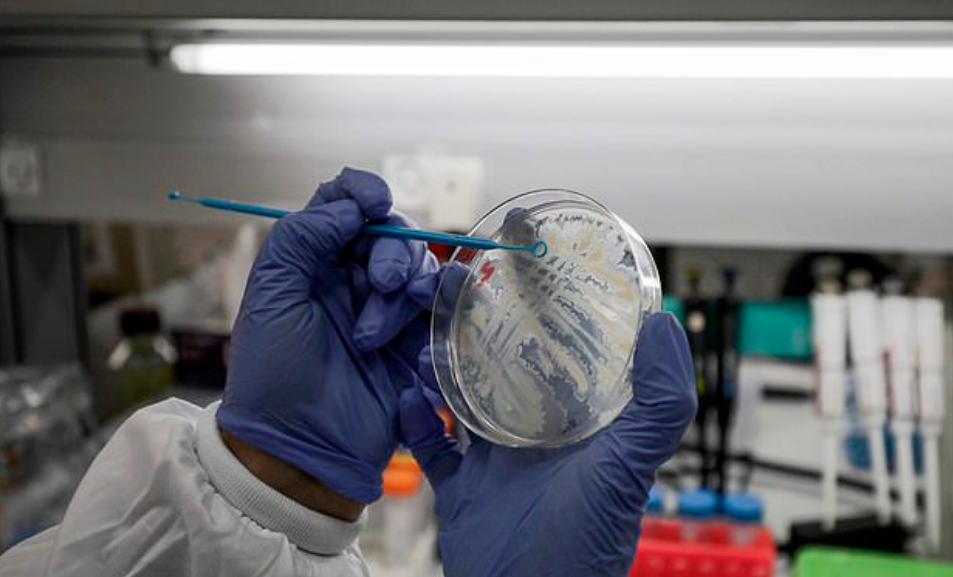

China has revealed it will be able to bring in vaccines for coronavirus for clinical use by next month after a lot of research as the total number of positive cases of the virus has crossed over 100,000 World Wide.
China has revealed that the scientists of the country had been striving to create a vaccination for immunization against the massive infection and they have been able to develop with 5 technologies currently working on it simultaneously.
“We estimate to drop the vaccination out by April for clinical and emergency use in hope that the vaccination can immunize the body and work against the virus,” said director of the Technical Development and Research Centre of China’s National Health Commission, Zheng Zhongwei.
Zheng said “Corona is a new virus and we have to understand as well as explore it thoroughly to develop a cure against it.
This is the same that applies to the vaccination as well. We have to try it and see if it works and check how to eliminate the problems associated.”
The authorities say that to develop the vaccination for the novel disease they had to assign a special team of experts.
Mr. Zheng said this at a conference of China’s Joint Prevention and Control Mechanism of the State Council.
He said that the team had to review more than a dozen companies just to make that one successful vaccination after working with 5 technologies simultaneously.
The virus has spread around the globe with cases rising every single day.
Till now more than 100,000 cases have been recorded around the world with 40,000 patients recovered from it already.
Several countries have locked down the holy places to prevent the spread of the virus and authorities have also generated preventive methods for it.
Share this post with your friends and family.
Recommended Video:
“Dad Comes Home After 16 Months Overseas And Surprises Daughter At Her Volleyball Practice”
[rumble video_id=vkkqx domain_id=u7nb2]
If you liked this post, we would love to hear from you:)